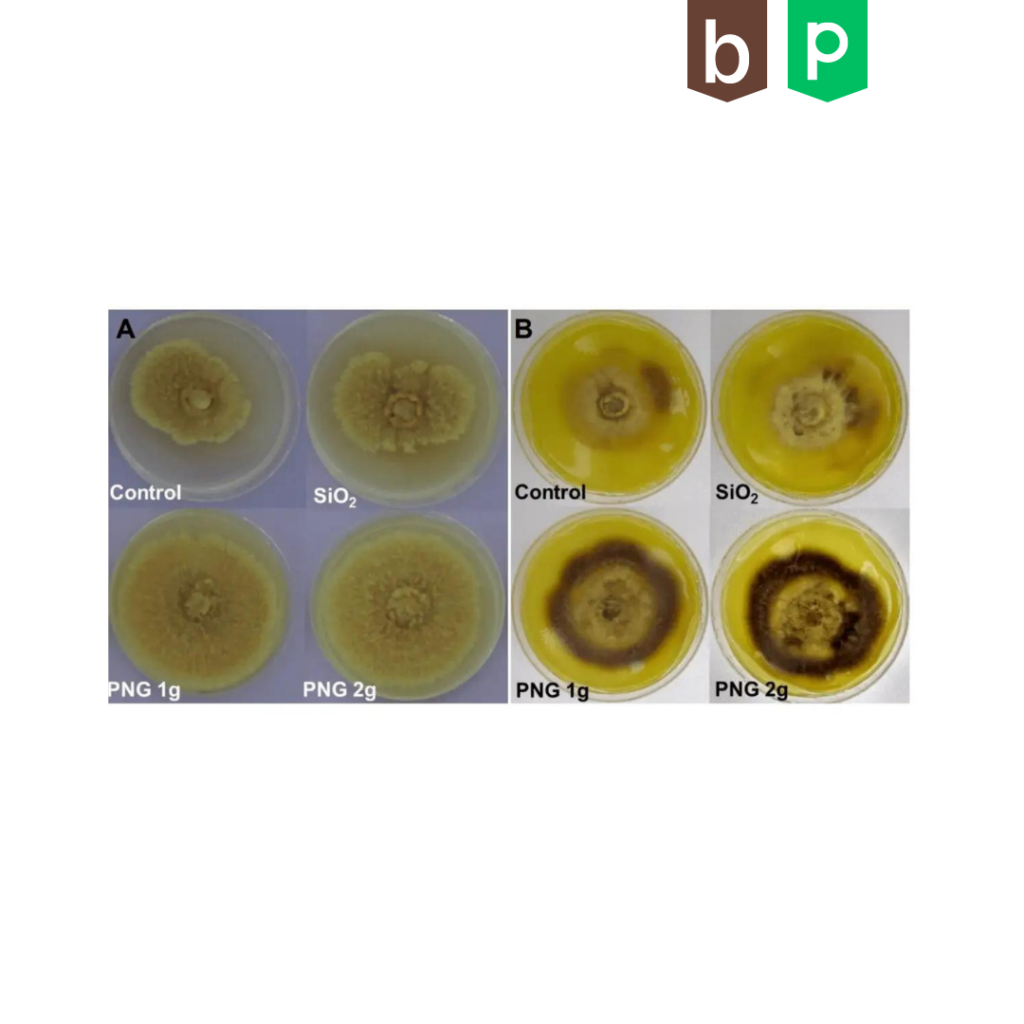

Besserer Ertrag im Mais

Mit den Penergetic Boden und Pflanzenprodukte konnte der Ertrag gesteigert werden. Das Kolbengewicht der Penergetic-Gruppe war im Durchschnitt…
Reduktion der Spritzkosten und 15% mehr Ernte durch penergetic p

Die Wirkung von penergetic p zeigt sich bei diesem Kartoffelversuch sehr schön: Kräftige Pflanzen und bedeutend weniger Düngerkosten.
Silomais mit Blattapplikation

Silomais ist ein wichtiges landwirtschaftliches Pflanzenfutter für Nutztiere in den USA. Mit penergetic behandelter Mais aus dem Bundesstaat…
Wissenschaftliche Veröffentlichung: In-vitro-Aktivierung von mikrobiellem Wachstum in niederfrequenten elektromagnetischen Feldern
„Bei der Verwendung des kommerziellen Biostimulators in Kulturmedium wurden signifikante Zunahmen des Pilz- und Bakterienwachstums beobachtet.“
…
Höheren Ertrag trotz verringerter Düngung

Bei einer um 20% reduzierten Kunstdüngerabgabe wurde dank den penergetic Produkten in beiden Jahren eine Ertragssteigerung erwirtschaftet. In…
77% Phosphorzunahme dank penergetic: Langzeitauswertung bei Anwendung auf Wiesen

Die Auswertung der ersten Testergebnissen von 2010 bis 2018 zeigt eine Zunahme von 77% Phosphor.
Der Durchschnitt des pflanzenverfügbaren P2O5 stieg…
Studie des Instituts für Landwirtschaft der Universität für Biowissenschaften Warschau-SGGW

Die an mehreren Standorten erzielten Ergebnisse bewiesen, dass es möglich ist, die Düngung der Zuckerrüben mit mineralischem Stickstoff um 30% zu…
Studie Universität Warschau: Stickstoff Dünger um 30% reduzieren und dennoch eine Ertragssteigerung erreichen

[…]Es wurde bestätigt, dass die beiden Kombinationen im Vergleich zur vollen Stickstoffdosis einen um 2,9% bzw. 8,8% höheren Ertrag an Maiskörnern…
Vorteile beim Kaffeeanbau bei der Verwendung von Zwischenfrüchten und Penergetic

Bei allen Behandlungen mit Penergetic und cover crops wurde der Kaffee-Trockenmasseertrag erhöht. Der Ertrag in Säcken/ha bei Verwendung von…
Jährliche Ertragssteigerung über 6 Jahre in Grossbritannien

Der 6-Jahres-Versuch in Grossbritannien zeigt eine allgemeine Ertragssteigerung aller getesteten Kulturen mit dem Einsatz von Penergetic b und…